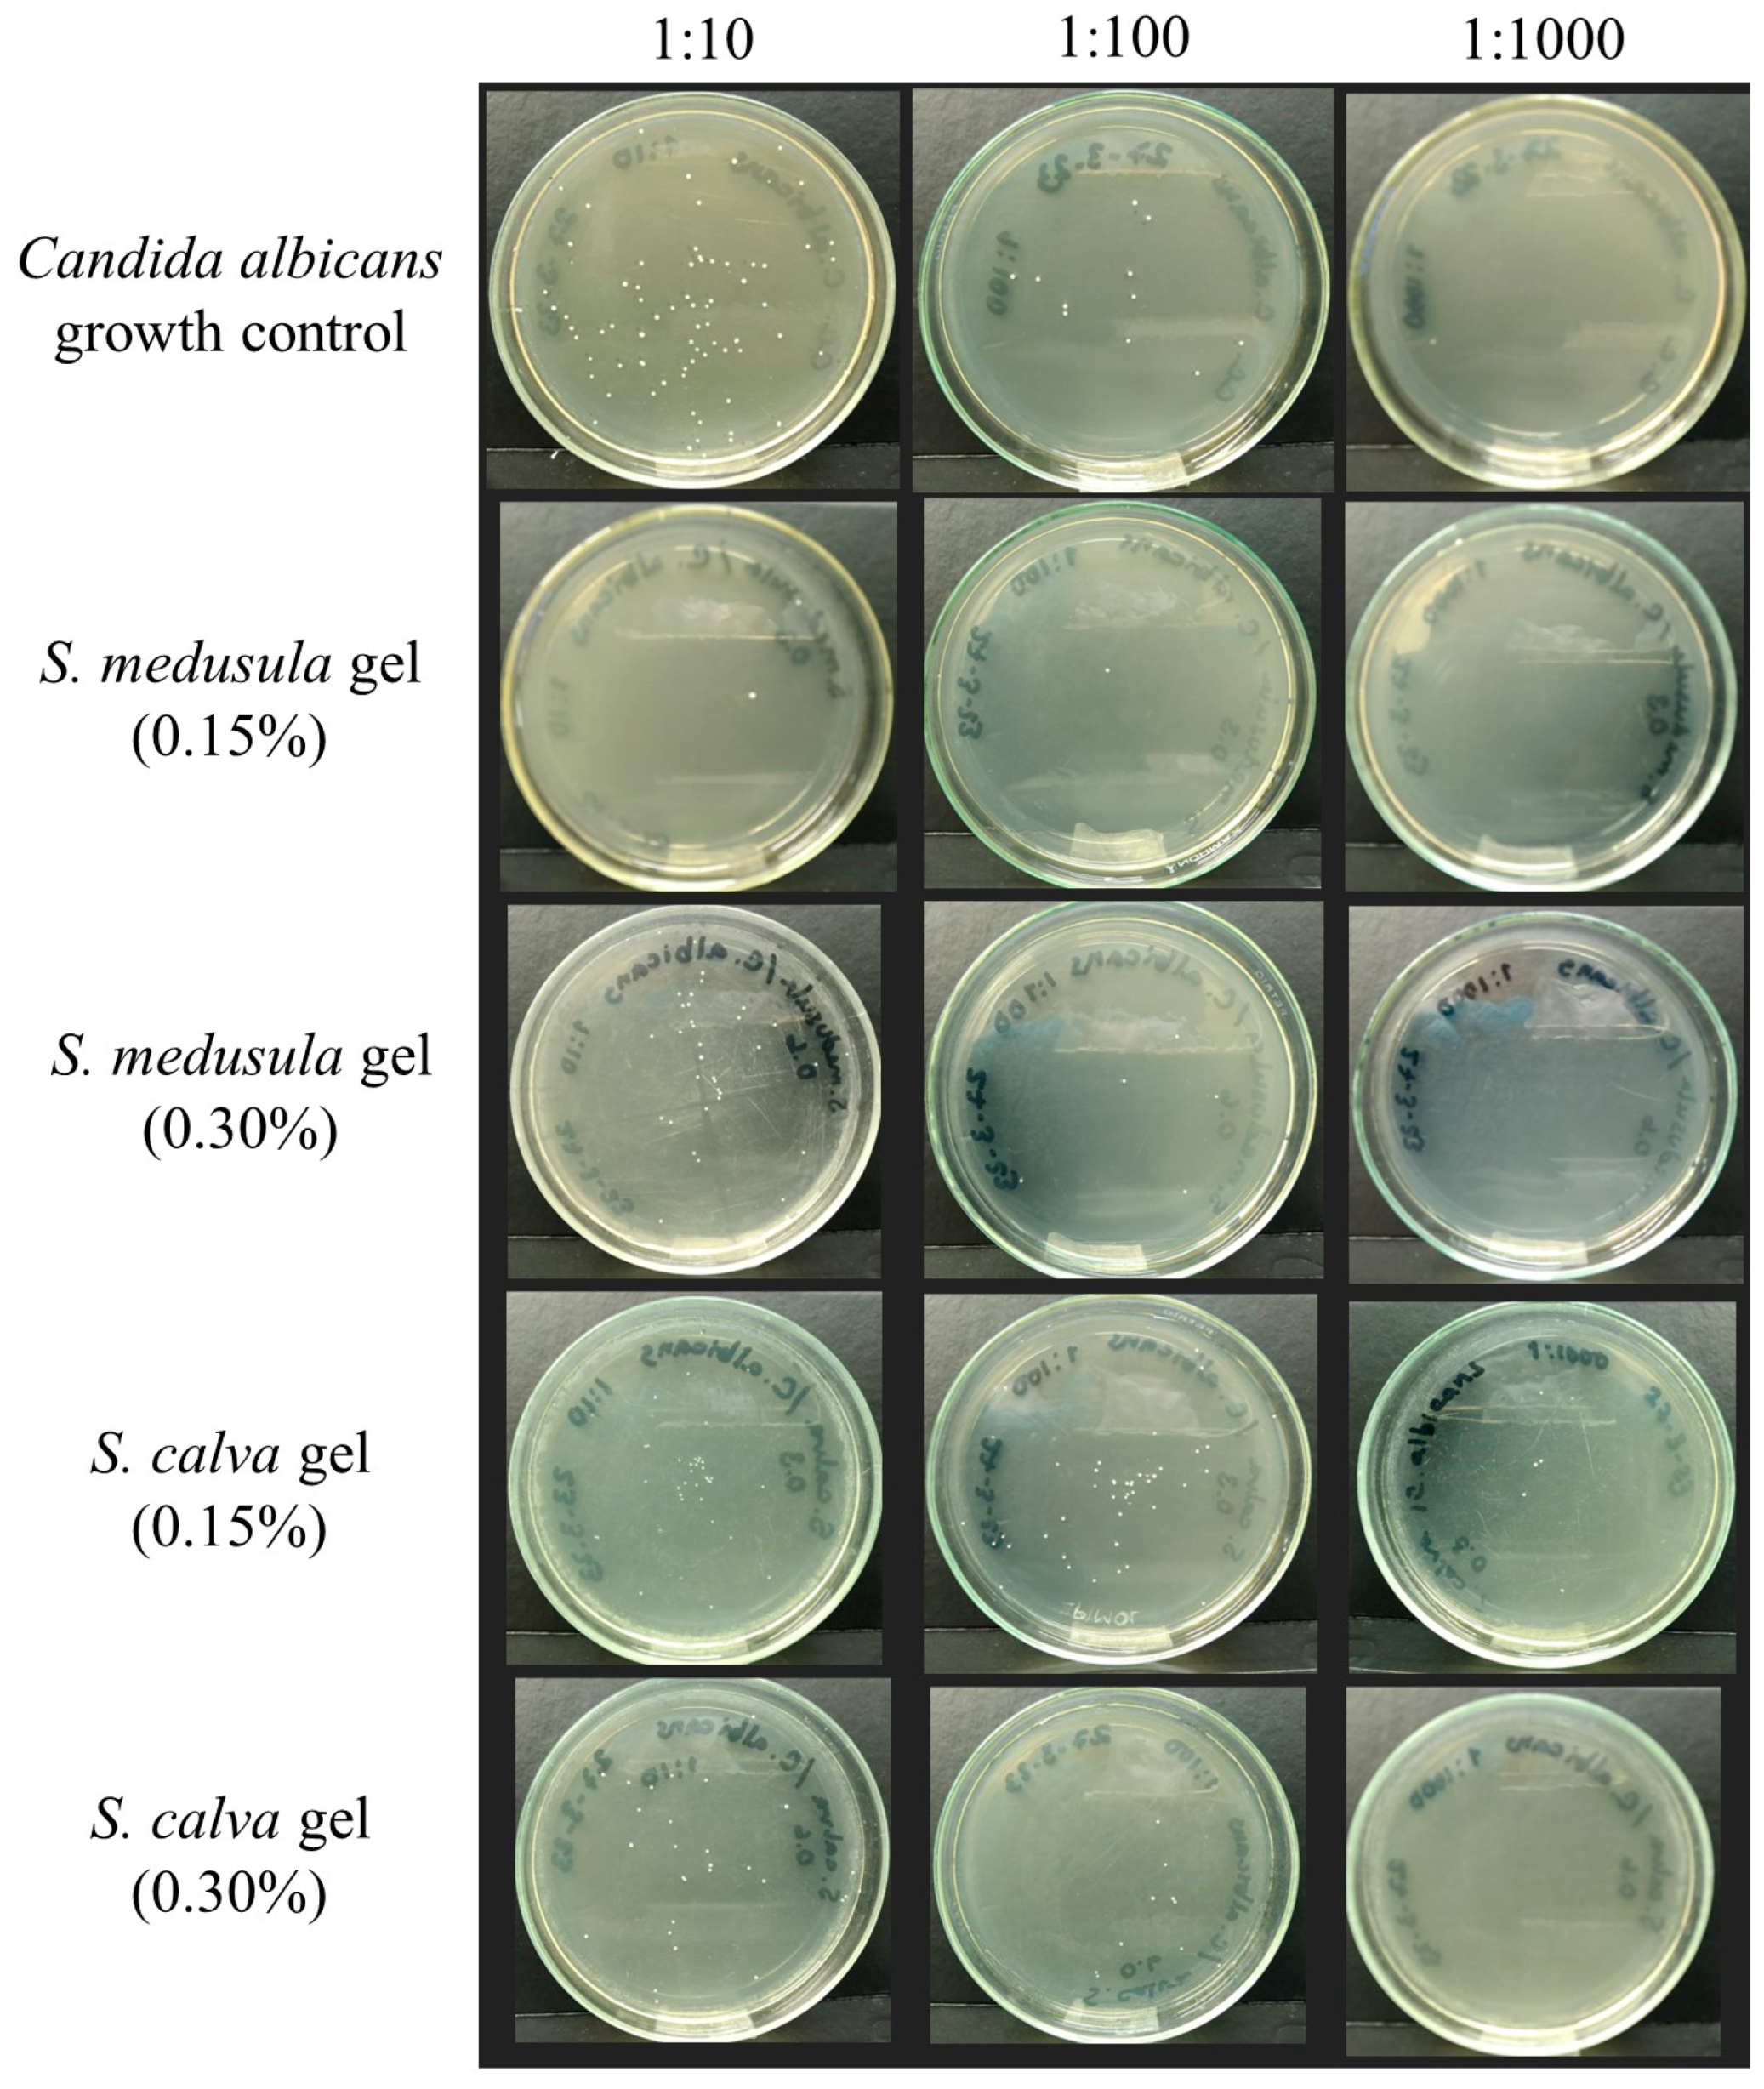
Pharmaceuticals 16 00990 g004

Exploring the Potential of Extracts from Sloanea medusula and S. calva: Formulating Two Skincare Gels with Antioxidant, Sun Protective Factor, and Anti-Candida albicans Activities
Abstract
1. Introduction
2. Results
2.1. Characterization of the Extracts
2.1.1. Chemical Composition of Ethanolic Extracts from Sloanea Species Leaves
2.1.2. Evaluation of the Antioxidant Activity of S. medusula and S. calva Extracts
2.1.3. Determination of in vitro Sun Protective Factor of Sloanea Extracts
2.1.4. Evaluation of the Anti-Candida Activity of Sloanea Extracts
2.2. Characterization of Sloanea-Extract-Based Gels
2.2.1. Physicochemical Characterization of the Gels
Organoleptic Properties of Gels
Rheology and Extensibility of Sloanea-Extract-Based Gels
2.2.2. Efficacy Studies
Evaluation of the Antioxidant Activity of Extract-Based Gels by DPPH Assay
Determination of in vitro Sun Protective Factor of Extract-Based Gels
Evaluation of the Anti-C. albicans Activity of Extract-Based Gels
2.3. Statistical Analysis
3. Discussion
4. Materials and Methods
4.1. Materials
4.2. Plant Material Collection and Extraction
4.3. HPLC-MS Analysis
4.4. DPPH Assay
4.5. Evaluation of Sun Protection Factor of Sloanea Extracts and Sloanea-Extract-Based Gels
4.6. Evaluation of the Inhibitory Effects of Extracts and Extract-Based Gels on the Growth of Candida albicans
4.6.1. Fungal Strain
4.6.2. Antifungal Susceptibility Testing
4.7. Preparation of Sloanea-Extract-Based Gels, Rheology, and Extensibility
5. Conclusions
Supplementary Materials
Author Contributions
Funding
Institutional Review Board Statement
Informed Consent Statement
Data Availability Statement
Acknowledgments
Conflicts of Interest
References
- Les, F.; Cásedas, G.; López, V. Bioactivity of Medicinal Plants and Extracts. Biology 2021, 10, 634. [Google Scholar] [CrossRef]
- Faccio, G. Plant Complexity and Cosmetic Innovation. iScience 2020, 23, 101358. [Google Scholar] [CrossRef] [PubMed]
- Guerranti, C.; Martellini, T.; Perra, G.; Scopetani, C.; Cincinelli, A. Microplastics in cosmetics: Environmental issues and needs for global bans. Environ. Toxicol. Pharmacol. 2019, 68, 75–79. [Google Scholar] [CrossRef]
- Nowak, K.; Jabłońska, E.; Ratajczak-Wrona, W. Controversy around parabens: Alternative strategies for preservative use in cosmetics and personal care products. Environ. Res. 2021, 198, 110488. [Google Scholar] [CrossRef] [PubMed]
- Consejo Nacional de Política Económica y Social. Política de Crecimiento Verde. In: CONPES 3934. 2018. Available online: https://www.minambiente.gov.co/wp-content/uploads/2021/08/conpes-3934-de-2018.pdf (accessed on 20 April 2023).
- Bharadvaja, N.; Gautam, S.; Singh, H. Natural polyphenols: A promising bioactive compounds for skin care and cosmetics. Mol. Biol. Rep. 2023, 50, 1817–1828. [Google Scholar] [CrossRef] [PubMed]
- Soleimani, S.; Yousefzadi, M.; Babaei Mahani Nezhad, S.; Pozharitskaya, O.N.; Shikov, A.N. Potential of the Ethyl Acetate Fraction of Padina boergesenii as a Natural UV Filter in Sunscreen Cream Formulation. Life 2023, 13, 239. [Google Scholar] [CrossRef]
- Sharma, R.R.; Deep, A.; Abdullah, S.T. Herbal products as skincare therapeutic agents against ultraviolet radiation-induced skin disorders. J. Ayurveda Integr. Med. 2022, 13, 100500. [Google Scholar] [CrossRef]
- Frazão, D.F.; Martins-Gomes, C.; Steck, J.L.; Keller, J.; Delgado, F.; Gonçalves, J.C.; Bunzel, M.; Pintado, C.M.B.S.; Díaz, T.S.; Silva, A.M. Labdanum Resin from Cistus ladanifer L.: A Natural and Sustainable Ingredient for Skin Care Cosmetics with Relevant Cosmeceutical Bioactivities. Plants 2022, 11, 1477. [Google Scholar] [CrossRef]
- Kim, C.; Park, J.; Lee, H.; Hwang, D.Y.; Park, S.H.; Lee, H. Evaluation of the EtOAc Extract of Lemongrass (Cymbopogon citratus) as a Potential Skincare Cosmetic Material for Acne Vulgaris. J. Microbiol. Biotechnol. 2022, 32, 594–601. [Google Scholar] [CrossRef]
- Pérez-Escobar, O.A.; Lucas, E.; Jaramillo, C.; Monro, A.; Morris, S.K.; Bogarín, D.; Greer, D.; Dodsworth, S.; Aguilar-Cano, J.; Sanchez Meseguer, A.; et al. The Origin and Diversification of the Hyperdiverse Flora in the Chocó Biogeographic Region. Front. Plant Sci. 2019, 10, 1328. [Google Scholar] [CrossRef] [PubMed]
- Vásquez-Ocmín, P.; Cojean, S.; Rengifo, E.; Suyyagh-Albouz, S.; Amasifuen Guerra, C.A.; Pomel, S.; Cabanillas, B.; Mejía, K.; Loiseau, P.M.; Figadère, B.; et al. Antiprotozoal activity of medicinal plants used by Iquitos-Nauta road communities in Loreto (Peru). J. Ethnopharmacol. 2018, 210, 372–385. [Google Scholar] [CrossRef]
- Cao, S.; Ranarivelo, L.; Ratsimbason, M.; Randrianasolo, S.; Ratovoson, F.; Andrianjafy, M.; Kingston, D.G. Antiplasmodial activity of compounds from Sloanea rhodantha (Baker) Capuron var. rhodantha from the Madagascar rain forest. Planta Med. 2006, 72, 1438–1440. [Google Scholar] [CrossRef]
- Rodriguez, N.; Vasquez, Y.; Hussein, A.A.; Coley, P.D.; Solis, P.N.; Gupta, M.P. Cytotoxic cucurbitacin constituents from Sloanea zuliaensis. J. Nat. Prod. 2003, 66, 1515–1516. [Google Scholar] [CrossRef]
- Khan, R.A. Natural products chemistry: The emerging trends and prospective goals. Saudi Pharm. J. 2018, 26, 739–753. [Google Scholar] [CrossRef] [PubMed]
- Palese, E.; Nudo, M.; Zino, G.; Devirgiliis, V.; Carbotti, M.; Cinelli, E.; Rodio, D.M.; Bressan, A.; Prezioso, C.; Ambrosi, C.; et al. Cutaneous candidiasis caused by Candida albicans in a young non-immunosuppressed patient: An unusual presentation. Int. J. Immunopathol. Pharmacol. 2018, 32, 1–4. [Google Scholar] [CrossRef] [PubMed]
- Talapko, J.; Juzbašić, M.; Matijević, T.; Pustijanac, E.; Bekić, S.; Kotris, I.; Škrlec, I. Candida albicans-The Virulence Factors and Clinical Manifestations of Infection. J. Fungi. 2021, 7, 79. [Google Scholar] [CrossRef]
- Taudorf, E.H.; Jemec, G.B.E.; Hay, R.J.; Saunte, D.M.L. Cutaneous candidiasis—An evidence-based review of topical and systemic treatments to inform clinical practice. J. Eur. Acad. Dermatol. 2019, 33, 1863–1873. [Google Scholar] [CrossRef]
- Healy, B.; Barnes, R. Topical and oral treatments for fungal skin infections. Prescriber 2006, 17, 30–43. [Google Scholar] [CrossRef]
- Al-Ghazzewi, F.H.; Tester, R.F. Impact of prebiotics and probiotics on skin health. Benef. Microbes 2014, 5, 99–107. [Google Scholar] [CrossRef]
- Yu, Y.; Dunaway, S.; Champer, J.; Kim, J.; Alikhan, A. Changing our microbiome: Probiotics in dermatology. Br. J. Dermatol. 2020, 182, 39–46. [Google Scholar] [CrossRef]
- Martínez, A.; Apip, C.; Meléndrez, M.F.; Domínguez, M.; Sánchez-Sanhueza, G.; Marzialetti, T.; Catalán, A. Dual antifungal activity against Candida albicans of copper metallic nanostructures and hierarchical copper oxide marigold-like nanostructures grown in situ in the culture medium. J. Appl. Microbiol. 2021, 130, 1883–1892. [Google Scholar] [CrossRef]
- Espinoza, L.C.; Sosa, L.; Granda, P.C.; Bozal, N.; Díaz-Garrido, N.; Chulca-Torres, B.; Calpena, A.C. Development of a Topical Amphotericin B and Bursera graveolens Essential Oil-Loaded Gel for the Treatment of Dermal Candidiasis. Pharmaceuticals 2021, 14, 1033. [Google Scholar] [CrossRef]
- Yamaguchi, K.K.D.L.; Souza, A.D.O. Antioxidant, hypoglycemic and neuroprotective activities of extracts from fruits native to the Amazon region: A review. Biotechnol. J. Int. 2020, 24, 9–31. [Google Scholar] [CrossRef]
- Proestos, C. The Benefits of Plant Extracts for Human Health. Foods 2020, 9, 1653. [Google Scholar] [CrossRef]
- Suphasomboon, T.; Vassanadumrongdee, S. Toward sustainable consumption of green cosmetics and personal care products: The role of perceived value and ethical concern. Sustain. Prod. Consum. 2022, 33, 230–243. [Google Scholar] [CrossRef]
- Dubey, S.K.; Dey, A.; Singhvi, G.; Pandey, M.M.; Singh, V.; Kesharwani, P. Emerging trends of nanotechnology in advanced cosmetics. Colloids Surf. B Biointerfaces 2022, 214, 112440. [Google Scholar] [CrossRef]
- Jain, P.; Taleuzzaman, M.; Kala, C.; Kumar Gupta, D.; Ali, A.; Aslam, M. Quality by design (Qbd) assisted development of phytosomal gel of Aloe vera extract for topical delivery. J. Liposome Res. 2021, 31, 381–388. [Google Scholar] [CrossRef]
- Caballero-Gallardo, K.; Quintero-Rincón, P.; Stashenko, E.E.; Olivero-Verbel, J. Photoprotective Agents Obtained from Aromatic Plants Grown in Colombia: Total Phenolic Content, Antioxidant Activity, and Assessment of Cytotoxic Potential in Cancer Cell Lines of Cymbopogon flexuosus L. and Tagetes lucida Cav. Essent. Oils Plants 2022, 11, 1693. [Google Scholar] [CrossRef]
- Khan, Z.U.; Khan, T.; Mannan, A.; Ali, A.; Ni, J. In Vitro and Ex Vivo Evaluation of Mangifera indica L. Extract-Loaded Green Nanoparticles in Topical Emulsion against Oxidative Stress and Aging. Biomedicines 2022, 10, 2266. [Google Scholar] [CrossRef]
- Carreau, P.J. Rheological equations from molecular network theories. Trans. Soc. Rheol. 1972, 16, 99–127. [Google Scholar] [CrossRef]
- Pérez-Bueno, T.; Rodríguez-Perdomo, Y.; Morales-Lacarrere, I.; Soler-Roger, D.M.; Martín-Viaña, N.P. Rheological behavior and extensibility of a semi-solid formulation of the aqueous extract of Rhizoma mangle L. Tecnol. Ciencia Ed. 2011, 26, 75–79. [Google Scholar]
- Palacios-Duque, L. Two new species of Sloanea (Elaeocarpaceae) from the Chocó (Colombia). Caldasia 2004, 26, 429–432. [Google Scholar]
- Palacios-Duque, L.; Baeza, C.M. Revisión de la sección Brevispicae del género Sloanea (Elaeocarpaceae) en Bolivia. Gayana Botánica 2013, 70, 257–266. [Google Scholar] [CrossRef]
- Palacios-Duque, L. S. chocoana, nueva especie de Elaeocarpaceae (subgen. Sloanea, sect. Brevispicae) de Colombia. Darwiniana Nueva Ser. 2007, 45, 83–87. [Google Scholar]
- Palacios Duque, L.; Fernández Alonso, J.L. A new and interesting species of Sloanea (Elaeocarpaceae) from the Colombian Pacific. Rev. Acad. Colomb. Cienc. 2005, XXIX, 179–182. [Google Scholar]
- Ecos del Bosque. Conocer es Comenzar a Proteger. Sloanea medusula. Available online: https://ecosdelbosque.com/plantas/sloanea-medusula (accessed on 20 April 2023).
- Sannomiya, M.; Rodrigues, C.M.; Oliveira, G.C.A.; Carvalho, J.C.S.; da Costa, L.S.; Spadari, C.C.; Ferreira, M.J.P.; Vilegas, W.; Ishida, K. Galloylquinic acid derivatives from Byrsonima fagifolia leaf extract and potential antifungal activity. J. Ethnopharmacol. 2022, 297, 115534. [Google Scholar] [CrossRef]
- Ng, L.T.; Lin, C.C.; Lu, C.M. Antioxidative effects of 6-methoxysorigenin and its derivatives from Rhamnus nakaharai. Chem. Pharm. Bull. 2007, 55, 382–384. [Google Scholar] [CrossRef]
- Salminen, J.P. Two-Dimensional Tannin Fingerprints by Liquid Chromatography Tandem Mass Spectrometry Offer a New Dimension to Plant Tannin Analyses and Help To Visualize the Tannin Diversity in Plants. J. Agric. Food Chem. 2018, 66, 9162–9171. [Google Scholar] [CrossRef]
- Setlhodi, R.; Mashile, B.; Izu, G.O.; Gbashi, S.; Mashele, S.S.; Bonnet, S.L.; Makhafola, T.; Chukwuma, C.I. Modeling the Influence of Extraction Temperature on the Ellag-itannin and Antioxidant Profiles of “Wonderful” Pomegranate Peel Using Advanced Chemometrics Analysis. Food Bioprocess Technol. 2023, 1–17. [Google Scholar] [CrossRef]
- Peršurić, Ž.; Saftić Martinović, L.; Malenica, M.; Gobin, I.; Pedisić, S.; Dragović-Uzelac, V.; Kraljević Pavelić, S. Assessment of the Biological Activity and Phenolic Composition of Ethanol Extracts of Pomegranate (Punica granatum L.) Peels. Molecules 2020, 25, 5916. [Google Scholar] [CrossRef]
- Speciale, A.; Muscarà, C.; Molonia, M.S.; Cristani, M.; Cimino, F.; Saija, A. Recent Advances in Glycyrrhetinic Acid-Functionalized Biomaterials for Liver Cancer-Targeting Therapy. Molecules 2022, 27, 1775. [Google Scholar] [CrossRef] [PubMed]
- Gupta, D.K.; Verma, M.K.; Anand, R.; Khajuria, R.K. Development of a validated UPLC-qTOF-MS/MS method for determination of bioactive constituent from Glycyrrhiza glabra. J. Pharm. Anal. 2013, 3, 205–210. [Google Scholar] [CrossRef] [PubMed]
- Jiang, T.; Xu, J.; Lu, Y.; Chen, X.; Li, Y. Network Pharmacology Analysis and Experimental Validation to Explore the Anti-inflammatory Mechanism of Asiatic Acid on Alcoholic Steatohepatitis. Mediat. Inflamm. 2022, 2022, 1708030. [Google Scholar] [CrossRef] [PubMed]
- Bharitkar, Y.P.; Banerjee, M.; Kumar, S.; Paira, R.; Meda, R.; Kuotsu, K.; Mondal, N.B. Search for a potent microbicidal spermicide from the isolates of Shorea robusta resin. Contraception 2013, 88, 133–140. [Google Scholar] [CrossRef]
- Kumar, S.; Bharitkar, Y.P.; Kumar, G.S.; Mondal, N.B. Asiatic acid, a non-detergent type spermicide: Exploration of plausible pathway of spermicidal action. Med. Chem. Res. 2016, 25, 1908–1915. [Google Scholar] [CrossRef]
- Liao, X.; Hu, F.; Chen, Z. A HPLC-MS method for profiling triterpenoid acids and triterpenoid esters in Osmanthus fragrans fruits. Analyst 2019, 144, 6981–6988. [Google Scholar] [CrossRef]
- Marcelino, S.; Mandim, F.; Taofiq, O.; Pires, T.C.S.P.; Finimundy, T.C.; Prieto, M.A.; Barros, L. Valorization of Punica granatum L. Leaves Extracts as a Source of Bioactive Molecules. Pharmaceuticals 2023, 16, 342. [Google Scholar] [CrossRef]
- Torgbo, S.; Rugthaworn, P.; Sukatta, U.; Sukyai, P. Biological Characterization and Quantification of Rambutan (Nephelium lappaceum L.) Peel Extract as a Potential Source of Valuable Minerals and Ellagitannins for Industrial Applications. ACS Omega 2022, 7, 34647–34656. [Google Scholar] [CrossRef]
- Chen, J.; Xu, Y.; Yang, Y.; Yao, X.; Fu, Y.; Wang, Y.; Liu, Y.; Wang, X. Evaluation of the Anticancer Activity and Mechanism Studies of Glycyrrhetic Acid Derivatives toward HeLa Cells. Molecules 2023, 28, 3164. [Google Scholar] [CrossRef]
- Diniz, L.R.L.; Calado, L.L.; Duarte, A.B.S.; de Sousa, D.P. Centella asiatica and Its Metabolite Asiatic Acid: Wound Healing Effects and Therapeutic Potential. Metabolites 2023, 13, 276. [Google Scholar] [CrossRef]
- Hsu, H.; Sheth, C.C.; Veses, V. Herbal Extracts with Antifungal Activity against Candida albicans: A Systematic Review. Mini Rev. Med. Chem. 2021, 21, 90–117. [Google Scholar] [CrossRef]
- He, H.; Li, A.; Li, S.; Tang, J.; Li, L.; Xiong, L. Natural components in sunscreens: Topical formulations with sun protection factor (SPF). Biomed. Pharmacother. 2021, 134, 111161. [Google Scholar] [CrossRef]
- Kaur, N.; Bains, A.; Kaushik, R.; Dhull, S.B.; Melinda, F.; Chawla, P. A Review on Antifungal Efficiency of Plant Extracts Entrenched Polysaccharide-Based Nanohydrogels. Nutrients 2021, 13, 2055. [Google Scholar] [CrossRef] [PubMed]
- Iyer, M.S.; Gujjari, A.K.; Paranthaman, S.; Abu Lila, A.S.; Almansour, K.; Alshammari, F.; Khafagy, E.S.; Arab, H.H.; Gowda, D.V. Development and Evaluation of Clove and Cinnamon Supercritical Fluid Extracts-Loaded Emulgel for Antifungal Activity in Denture Stomatitis. Gels 2022, 8, 33. [Google Scholar] [CrossRef] [PubMed]
- Aldawsari, H.M.; Badr-Eldin, S.M.; Labib, G.S.; El-Kamel, A.H. Design and formulation of a topical hydrogel integrating lemongrass-loaded nanosponges with an enhanced antifungal effect: In vitro/in vivo evaluation. Int. J. Nanomed. 2015, 10, 893–902. [Google Scholar] [CrossRef]
- Sierra, L.J.; Córdoba, Y.; Mejía, J.J.; Rueda, E.Q.; Ocazionez, R.E.; Avila-Acevedo, J.G.; García-Bores, A.M.; Espinosa-González, A.M.; Benitez-Flores, J.; González-Valle, M.; et al. Photoprotective activity of Ipomoea horsfalliae flower extract. Rev. Bras. Farmacogn. 2020, 30, 69–79. [Google Scholar] [CrossRef]
- García Forero, A.; Villamizar Mantilla, D.A.; Núñez, L.A.; Ocazionez, R.E.; Stashenko, E.E.; Fuentes, J.L. Photoprotective and Antigenotoxic Effects of the Flavonoids Apigenin, Naringenin and Pinocembrin. Photochem. Photobiol. 2019, 95, 1010–1018. [Google Scholar] [CrossRef]
- Zapata-Zapata, C.; Loaiza-Oliva, M.; Martínez-Pabón, M.C.; Stashenko, E.E.; Mesa-Arango, A.C. In Vitro Activity of Essential Oils Distilled from Colombian Plants against Candida auris and Other Candida Species with Different Antifungal Susceptibility Profiles. Molecules 2022, 27, 6837. [Google Scholar] [CrossRef]
- Gil-González, M.; Gómez-Velásquez, J.C.; Loaiza-Díaz, N.; Florez-Muñoz, S.V.; Hernández-Herrera, G.N.; Mesa-Arango, A.C. Onychomycosis caused by the environmental mold Neoscytalidium dimidiatum in Colombia, and in vitro antifungal susceptibility evaluation. Med. Mycol. 2020, 59, 634–637. [Google Scholar] [CrossRef]
- Assimopoulou, A.N.; Sinakos, Z.; Papageorgiou, V.P. Radical scavenging activity of Crocus sativus L. extract and its bioactive constituents. Phytother. Res. 2005, 19, 997–1000. [Google Scholar] [CrossRef]
- Tampucci, S.; Burgalassi, S.; Chetoni, P.; Monti, D. Cutaneous permeation and penetration of sunscreens: Formulation strategies and in vitro methods. Cosmetics 2018, 5, 1. [Google Scholar] [CrossRef]
- Nciki, S.; Oderinlo, O.O.; Gulube, Z.; Osamudiamen, P.M.; Idahosa, K.C.; Patel, M. Mezoneuron benthamianum inhibits cell adherence, hyphae formation, and phospholipase production in Candida albicans. Archiv. Microbiol. 2020, 202, 2533–2542. [Google Scholar] [CrossRef] [PubMed]
- Mondal, S.; Bandyopadhyay, A. Photoprotective, antioxidant potential and DNA damage protection assay of leaf methanolic extract of Holoptelea integrifolia (Roxb) Planch and determination of some bioactive phenolic compounds by RP-HPLC. Biocatal. Agric. Biotechnol. 2023, 50, 102728. [Google Scholar] [CrossRef]
- Tóth, Z.; Forgács, L.; Kardos, T.; Kovács, R.; Locke, J.B.; Kardos, G.; Nagy, F.; Borman, A.M.; Adnan, A.; Majoros, L. Relative Frequency of Paradoxical Growth and Trailing Effect with Caspofungin, Micafungin, Anidulafungin, and the Novel Echinocandin Rezafungin against Candida Species. J. Fungi 2020, 6, 136. [Google Scholar] [CrossRef] [PubMed]
- Wagemaker, T.A.; Silva, S.A.; Leonardi, G.R.; Campos, P.M.M. Green Coffea arabica L. seed oil influences the stability and protective effects of topical formulations. Ind. Crops Prod. 2015, 63, 34–40. [Google Scholar] [CrossRef]
- Tak, U.N.; Rashid, S.; Kour, P.; Nazir, N.; Zargar, M.I.; Dar, A.A. Bergenia stracheyi extract-based hybrid hydrogels of biocompatible polymers with good adhesive, stretching, swelling, self-healing, antibacterial, and antioxidant properties. Int. J. Biol. Macromol. 2023, 234, 123718. [Google Scholar] [CrossRef]
- Millsop, J.W.; Fazel, N. Oral candidiasis. Clin. Dermatol. 2016, 34, 487–494. [Google Scholar] [CrossRef]
- Wohlrab, J.; Gebert, A. pH and Buffer Capacity of Topical Formulations. Curr. Probl. Dermatol. 2018, 54, 123–131. [Google Scholar] [CrossRef]
- Angelova-Fischer, I.; Fischer, T.W.; Abels, C.; Zillikens, D. Accelerated barrier recovery and enhancement of the barrier integrity and properties by topical application of a pH 4 vs. a pH 5·8 water-in-oil emulsion in aged skin. Br. J. Dermatol. 2018, 179, 471–477. [Google Scholar] [CrossRef]
- Soto-García, M.; Rosales-Castro, M. Efecto del solvente y de la relación masa/solvente, sobre la extracción de compuestos fenólicos y la capacidad antioxidante de extractos de corteza de Pinus durangensis y Quercus sideroxyla. Maderas Cienc. Technol. 2016, 18, 701–714. [Google Scholar] [CrossRef]
- Wang, M.; Carver, J.J.; Phelan, V.V.; Sanchez, L.M.; Garg, N.; Peng, Y.; Nguyen, D.D.; Watrous, J.; Kapono, C.A.; Luzzatto-Knaan, T.; et al. Sharing and community curation of mass spectrometry data with Global Natural Products Social Molecular Networking. Nat. Biotechnol. 2016, 34, 828–837. [Google Scholar] [CrossRef] [PubMed]
- Rahman, M.M.; Islam, M.B.; Biswas, M.; Khurshid Alam, A.H. In vitro antioxidant and free radical scavenging activity of different parts of Tabebuia pallida growing in Bangladesh. BMC Res. Notes 2015, 8, 621. [Google Scholar] [CrossRef]
- Brand-Williams, W.; Cuvelier, M.E.; Berset, C.L.W.T. Use of a free radical method to evaluate antioxidant activity. LWT Food Sci. Technol. 1995, 28, 25–30. [Google Scholar] [CrossRef]
- De Souza Mansur, J.; Breder, M.N.R.; dAscensão Mansur, M.C.; Azulay, R.D. Determination of sun protecting factor in human beings and by spectrophotometry: Comparison between of the two methods. An. Bras. Dermatol. 1986, 61, 167–172. [Google Scholar]
- Sayre, R.M.; Agin, P.P.; LeVee, G.J.; Marlowe, E. A comparison of in vivo and in vitro testing of sun screening formulas. Photochem. Photobiol. 1979, 29, 559–566. [Google Scholar] [CrossRef]
- da Fonseca, E.Q.; da Silva, G.F.; Maquiné, L.V.; Matsdorff, Y.; Monteiro, R.S.G.; Aranha, E.S.P.; de Vasconcellos, M.; Albuquerque, P.M. Photoprotective, antioxidant, antimicrobial and cytotoxic activities of guarana (Paullinia cupana) seed extracts. Int. J. Phytocos. Nat. Ingred. 2020, 7, 10. [Google Scholar] [CrossRef]
- Radice, M.; Manfredini, S.; Ziosi, P.; Dissette, V.; Buso, P.; Fallacara, A.; Vertuani, S. Herbal extracts, lichens and biomolecules as natural photoprotection alternatives to synthetic UV filters. A systematic review. Fitoterapia 2016, 114, 144–162. [Google Scholar] [CrossRef]
- CLSI. Reference Method for Broth Dilution Antifungal Susceptibility Testing of Yeasts. In CLSI Standard M27, 4th ed.; Clinical and Laboratory Standards Institute: Wayne, PA, USA, 2017. [Google Scholar]
- Correa-Royero, J.; Tangarife, V.; Durán, C.; Stashenko, E.; Mesa-Arango, A. In vitro antifungal activity and cytotoxic effect of essential oils and extracts of medicinal and aromatic plants against Candida krusei and Aspergillus fumigatus. Rev. Bras. Farmacogn. 2010, 20, 734–741. [Google Scholar] [CrossRef]

| No. | TR (min) | Adduct | Estimated Mass (m/z) | Exact Mass [M] (g/mol) | Structural Formula | Error (ppm) | Tentative Annotation |
|---|---|---|---|---|---|---|---|
| 1 | 9.882 | M-H | 293.17583 | 294.18367 | C17H26O4 | −2.8 | Glycolic acid 4-hydroxy-3,5-di-t-butylbenzyl ester |
| 2 | 3.4207 | M-H | 539.1230 | 540.14734 | C24H28O14 | 2.5 | α-Sorinin |
| 3 | 3.2289 | M-H | 952.08289 | 952.08289 | C41H28O27 | 2.1 | Geraniin |
| 476.03300 | |||||||
| 4 | 3.2289 | M-H | 952.08289 | 952.08289 | C41H28O27 | 2.1 | Granatin B |
| 476.03300 |
| No. | TR (min) | Adduct | Estimated Mass (m/z) | Exact Mass [M] (g/mol) | Structural Formula | Error (ppm) | Tentative Annotation |
|---|---|---|---|---|---|---|---|
| 1 | 9.882 | M-H | 293.17583 | 294.18367 | C17H26O4 | −2.8 | Glycolic acid 4-hydroxy-3,5-di-t-butylbenzyl ester |
| 2 | 8.044 | M+H | 471.346886 | 470.33905 | C30H46O4 | −0.1 | Uralenic acid, glycyrrhetinic acid |
| 3 | 5.953 | M+H | 489.357451 | 488.34961 | C30H48O5 | −0.0 | Asiatic acid |
| 4 | 4.389 | M+H | 615.389145 | 614.38131 | C36H54O8 | −0.1 | Asiatic acid triacetate |
| Extract | DPPH a Radical Scavenging Activity (%) MEAN ± SEM (n = 3) | TEAC b MEAN ± SEM (n = 3) |
|---|---|---|
| S. medusula | 42.4 ± 0.0 | 1.1 ± 0.0 |
| S. calva | 44.7 ± 0.0 | 2.7 ± 0.0 |
| Extract | SPF a MEAN ± SEM (n = 3) | ||
|---|---|---|---|
| 0.25 mg/mL | 0.5 mg/mL | 0.75 mg/mL | |
| S. medusula | 16.9 ± 0.1 b | 26.7 ± 0.6 c | 32.5 ± 0.4 d |
| S. calva | 19.7 ± 0.1 c | 30.2 ± 0.2 d | 35.4 ± 0.2 d |
| Extract | Anti-Candida Activity, GM-MIC a (µg/mL) | ||||
|---|---|---|---|---|---|
| C. krusei ATCC 6258 (L6) | C. auris Ca17 (L25) | C. tropicalis ATCC 200956 | C. glabrata LMDM 34 (L7) | C. albicans ATCC 10231 | |
| S. medusula | 32.0 | 16.0 | 32.0 | 22.6 | 2.0 |
| S. calva | 2.0 | >256 | 4.0 | >256 | 2.0 |
| Itraconazole | 0.125 | - | - | - | - |
| Amphotericin B | 0.630 | - | - | - | - |
| Extract-Based Gel | DPPH a Radical Scavenging Activity (%) MEAN ± SEM (n = 3) | TEAC b MEAN ± SEM (n = 3) |
|---|---|---|
| S. medusula gel | 54.5 ± 0.0 | 22.9 ± 0.0 |
| S. calva gel | 53.0 ± 0.0 | 20.3 ± 0.0 |
| Formulation | SPF a MEAN ± SEM (n = 3) |
|---|---|
| S. medusula gel | 60.0 ± 0.0 b |
| S. calva gel | 57.3 ± 0.4 b |
| Sunscreen 1 f | 60.0 ± 0.0 b |
| Sunscreen 2 f | 47.1 ± 0.0 c |
| Base gel | 21.8 ± 0.6 d |
| Gel, Final Concentration Evaluated (%) | GM-CFU/mL a | Growth Inhibition (%) |
|---|---|---|
| S. medusula gel (0.15) | 1260 * | 98 |
| S. medusula gel (0.30) | 18,110 * | 73 |
| S. calva gel (0.15) | 36,617 * | 46 |
| S. calva gel (0.30) | 16,080 * | 76 |
| Base gel b | 67,824 | 0 |
| Wavelength (λ, nm) | EE (λ) × I (λ) |
|---|---|
| 290 | 0.015 |
| 295 | 0.082 |
| 300 | 0.287 |
| 305 | 0.328 |
| 310 | 0.186 |
| 315 | 0.084 |
| 320 | 0.018 |
| Composition of Formulation, Concentration | S. medusula Gel | S. calva Gel |
|---|---|---|
| Carbopol® Ultrez 21 Polymer, % w/w | 0.46 | 0.7 |
| Sodium nipagin, % w/w | 0.2 | 0.2 |
| Triethanolamine, % w/v | 1.0 | 1.0 |
| Glycerine, % w/v | 6.0 | 6.0 |
| Deionized water, q.s.p., % w/v | 100 | 100 |
| Extract of Sloanea species, % w/w | 0.3 | 0.3 |
Disclaimer/Publisher’s Note: The statements, opinions and data contained in all publications are solely those of the individual author(s) and contributor(s) and not of MDPI and/or the editor(s). MDPI and/or the editor(s) disclaim responsibility for any injury to people or property resulting from any ideas, methods, instructions or products referred to in the content. |
© 2023 by the authors. Licensee MDPI, Basel, Switzerland. This article is an open access article distributed under the terms and conditions of the Creative Commons Attribution (CC BY) license (https://creativecommons.org/licenses/by/4.0/).
Share and Cite
Quintero-Rincón, P.; Mesa-Arango, A.C.; Flórez-Acosta, O.A.; Zapata-Zapata, C.; Stashenko, E.E.; Pino-Benítez, N. Exploring the Potential of Extracts from Sloanea medusula and S. calva: Formulating Two Skincare Gels with Antioxidant, Sun Protective Factor, and Anti-Candida albicans Activities. Pharmaceuticals 2023, 16, 990. https://doi.org/10.3390/ph16070990
Quintero-Rincón P, Mesa-Arango AC, Flórez-Acosta OA, Zapata-Zapata C, Stashenko EE, Pino-Benítez N. Exploring the Potential of Extracts from Sloanea medusula and S. calva: Formulating Two Skincare Gels with Antioxidant, Sun Protective Factor, and Anti-Candida albicans Activities. Pharmaceuticals. 2023; 16(7):990. https://doi.org/10.3390/ph16070990
Chicago/Turabian StyleQuintero-Rincón, Patricia, Ana C. Mesa-Arango, Oscar A. Flórez-Acosta, Carolina Zapata-Zapata, Elena E. Stashenko, and Nayive Pino-Benítez. 2023. "Exploring the Potential of Extracts from Sloanea medusula and S. calva: Formulating Two Skincare Gels with Antioxidant, Sun Protective Factor, and Anti-Candida albicans Activities" Pharmaceuticals 16, no. 7: 990. https://doi.org/10.3390/ph16070990
APA StyleQuintero-Rincón, P., Mesa-Arango, A. C., Flórez-Acosta, O. A., Zapata-Zapata, C., Stashenko, E. E., & Pino-Benítez, N. (2023). Exploring the Potential of Extracts from Sloanea medusula and S. calva: Formulating Two Skincare Gels with Antioxidant, Sun Protective Factor, and Anti-Candida albicans Activities. Pharmaceuticals, 16(7), 990. https://doi.org/10.3390/ph16070990

